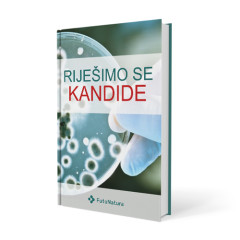
Riješimo se kandide

0
Zatvori
Vaša košarica
je prazna!
je prazna!


Internetska stranica upotrebljava kolačiće uz pomoć kojih poboljšavamo korisničko iskustvo i osiguravamo vam sadržaj. Neki su nužni za pravilno funkcioniranje stranice, dok su drugi izborni. Više informacija
Ponedjeljak - četvrtak: 8.00 - 16.00
Petak: 8.00 - 14.00
Mogućnost kartičnog plaćanja. Osigurana zaštita osobnih podataka preko SSL kodiranja.
Mogućnost kartičnog plaćanja. Osigurana zaštita osobnih podataka preko SSL kodiranja.